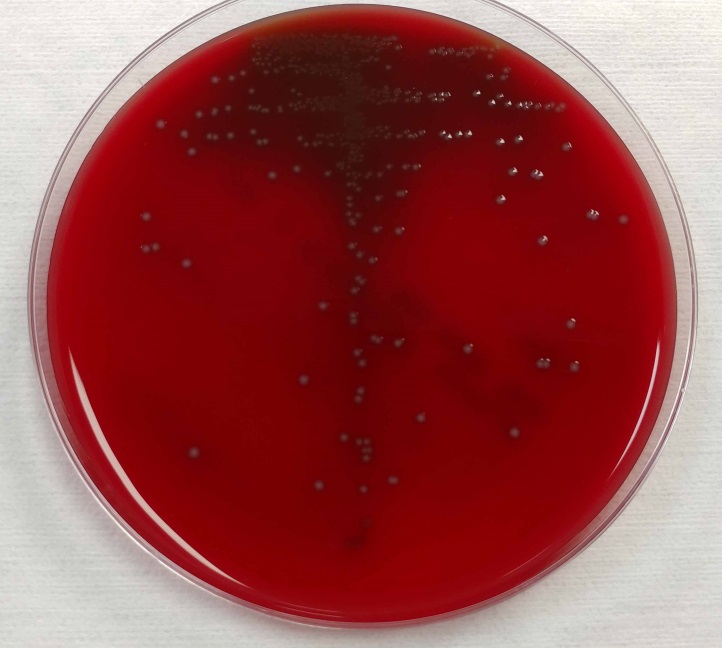
streplut

Case History
An 11 year-old patient with a history of a relapsed lymphoma presented to the hematology/oncology clinic with worsening abdominal pain. The patient was recently started on metronidazole to treat a C. difficile infection. In the clinic, the patient was found to be hypotensive, hypoxemic and pancytopenic. Blood cultures were drawn and the patient was admitted directly to the pediatric ICU and started on empiric antibiotics.
The blood cultures turned positive with Gram-positive cocci, which went on to produce small, gray, alpha-hemolytic colonies on the blood agar plate (Image 1). The colonies were catalase negative and PYR negative. The isolate was analyzed by a Bruker MALDI-TOF mass spectrometer and was identified as Streptococcus lutetiensis (score 2.19). Susceptibility testing revealed the isolate susceptible to ceftriaxone, penicillin, and vancomycin.
Image 1. 5% sheep blood agar growing small, grey, alpha-hemolytic colonies
Discussion
S. lutetiensis is part of the complex of organisms previously identified as the Streptococcus bovis group. This group of organisms, which possess the Lancefield Group D antigen, has undergone considerable reclassification schemes as phenotypes and genotypes have been investigated. The original biochemical classification schemes were based on their ability to ferment mannitol as well as the presence or absence of beta-glucuronidase activity. Early observations of the DNA properties from these organisms, such as %-GC base content and DNA-DNA hybridizations, identified six unique clusters of Group D streptococci [1]. One cluster group (cluster group #4) had heterogeneous biochemical phenotypes. A subcluster of this cluster group #4 was separated from the other members of the cluster based upon esculin hydrolysis. This subcluster would later go on to be named S. infantarius, so named as several isolates originated from the feces of human infants [2].
Further DNA-DNA hybridizations and ribotyping analysis led to the declaration of two S. infantarius subspecies: subsp. infantarius and subsp. coli [3]. The 16S rRNA ribotyping was problematic, however, as several species in this genus are 97-99% sequence identical.
In an attempt to address some of the limitations of relying on the 16S rRNA gene, one group analyzed the features of the conserved gene encoding the manganese-dependent superoxide dismutase gene (sodA). They observed substantial differences between S. infantarius subsp. infantarius and S. infantarius subsp. coli [4]. Thus, for the latter organism, a new species of streptococci was proposed: S. lutetiensis. It was named for Lutetia, a historical name for the city of Paris [4].
The species designation S. lutetiensis was not widely accepted, however. Based on further DNA-DNA hybridization experiments and the prior studies of the 16S rRNA, others have rejected the species name “S. lutetiensis” and maintain that it is a subspecies of S. infantarius as previously described [5].
So which name is correct? There appears to be no clear consensus about the designation of these streptococci, whether it is S. infantarius subsp. coli or whether it is another species altogether as S. lutetiensis. The Judicial Commission of the International Committee on Systematic Bacteriology reportedly met to discuss the name changes, however no resolution appears to have been determined [6]. Both names are seen in the literature as well as the names for reference organisms.
The important clinical aspect to recognize is that this organism, as well as the S. bovis group in general, can be a cause of bacteremia, endocarditis, and meningitis in children. Treatment with beta-lactam antibiotics is generally sufficient to cover these organisms.
References
- Farrow, J., et al., Taxonomic Studies on Streptococcus bovis and Streptococcus equinus: Description of Streptococcus alactolyticus sp. nov. and Streptococcus saccharolyticus sp nov. System. Appl. Microbiol, 1984. 5: p. 467-482.
- Bouvet, A., et al., Streptococcus infantarius sp. nov. related to Streptococcus bovis and Streptococcus equinus. Adv Exp Med Biol, 1997. 418: p. 393-5.
- Schlegel, L., et al., Streptococcus infantarius sp. nov., Streptococcus infantarius subsp. infantarius subsp. nov. and Streptococcus infantarius subsp. coli subsp. nov., isolated from humans and food. Int J Syst Evol Microbiol, 2000. 50 Pt 4: p. 1425-34.
- Poyart, C., G. Quesne, and P. Trieu-Cuot, Taxonomic dissection of the Streptococcus bovis group by analysis of manganese-dependent superoxide dismutase gene (sodA) sequences: reclassification of ‘Streptococcus infantarius subsp. coli’ as Streptococcus lutetiensis sp. nov. and of Streptococcus bovis biotype 11.2 as Streptococcus pasteurianus sp. nov. Int J Syst Evol Microbiol, 2002. 52(Pt 4): p. 1247-55.
- Schlegel, L., et al., Reappraisal of the taxonomy of the Streptococcus bovis/Streptococcus equinus complex and related species: description of Streptococcus gallolyticus subsp. gallolyticus subsp. nov., S. gallolyticus subsp. macedonicus subsp. nov. and S. gallolyticus subsp. pasteurianus subsp. nov. Int J Syst Evol Microbiol, 2003. 53(Pt 3): p. 631-45.
- Beck, M., R. Frodl, and G. Funke, Comprehensive study of strains previously designated Streptococcus bovis consecutively isolated from human blood cultures and emended description of Streptococcus gallolyticus and Streptococcus infantarius subsp. coli. J Clin Microbiol, 2008. 46(9): p. 2966-72.

-I.J. Frame MD, PhD, is a 1st year Clinical Pathology Resident at UT Southwestern Medical Center.

–Erin McElvania TeKippe, PhD, D(ABMM), is the Director of Clinical Microbiology at Children’s Medical Center in Dallas Texas and an Assistant Professor of Pathology and Pediatrics at University of Texas Southwestern Medical Center.




















